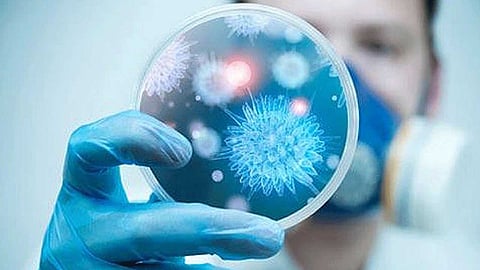

قال أحد أعضاء البرلمان الياباني عن الحزب الحاكم اليوم الإثنين إن بلاده تعتزم إعادة المئات من مواطنيها الموجودين بمدينة ووهان بوسط الصين؛ حيث ظهر فيروس كورونا الجديد.
وصرح توشيهيرو نيكاي الأمين العام للحزب الليبرالي الديمقراطي بأن طوكيو تخطط لإرسال طائرة إلى عاصمة مقاطعة هوبى في وقت مبكر من يوم غد الثلاثاء؛ لإجلاء المواطنين اليابانيين الذين يرغبون في العودة إلى ديارهم.
وقال وزير الخارجية الياباني توشيميتسو موتيجي إن الحكومة أكدت أن نحو 560 مواطنًا يابانيًا يعيشون في المقاطعة.
وكانت اليابان قد أعلنت أمس الأحد عن تسجيل إصابة شخص رابع بالفيروس القاتل في وسط اليابان.
اقرأ أيضًا: